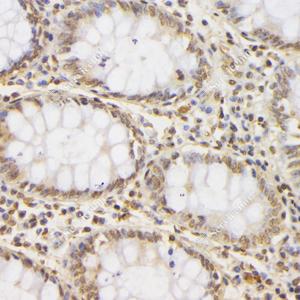

Anti-Phospho-JNK (T183/Y185) Mouse mAb
- 50 μL
产品信息
|
蛋白质全称 |
促分裂原活化蛋白激酶8/9/10 |
|
别名 |
JNK1 + JNK2 + JNK3, JNK1/2/3, JNK1+2+3, MAPK8, MAPK9, MAPK10, c Jun N terminal kinase 1, c Jun N terminal kinase 2, c Jun N terminal kinase 3, P-JNK |
|
Uniprot ID |
P45983/P45984/P53779 |
|
免疫原 |
KLH偶联的人JNK(T183/Y185)合成肽 |
|
抗体亚型 |
IgG2b, κ |
|
克隆号 |
8F8C2 |
|
预测分子量./观测分子量. |
46/54 kDa / 46/54 kDa |
|
纯化方式 |
亲和纯化 |
|
亚细胞定位 |
细胞质, 细胞核 |
应用
| 应用 | 物种 | 稀释 | 阳性样品 |
| WB 免疫印迹 | 人 | 1: 500-1: 1000 | HT-29细胞 |
| IHC/IF 免疫组织化学/免疫荧光 | 人 | 1: 500-1: 1000 | 卵巢癌,食道癌, 结肠癌 |
背景
The protein encoded by this gene is a member of the MAP kinase family. MAP kinases act as an integration point for multiple biochemical signals, and are involved in a wide variety of cellular processes such as proliferation, differentiation, transcription regulation and development. This kinase targets specific transcription factors, and thus mediates immediate-early gene expression in response to various cell stimuli. It is most closely related to MAPK8, both of which are involved in UV radiation induced apoptosis, thought to be related to the cytochrome c-mediated cell death pathway. This gene and MAPK8 are also known as c-Jun N-terminal kinases.
图像
|
|
WB检测Phospho-JNK (T183/Y185)蛋白(货号 GB12018). 样品: 经RIPA裂解液(货号G2002)处理的蛋白质. 封闭: 3%脱脂牛奶(货号GC310001)溶于TBST溶液, 室温孵育1小时. —抗: 1: 1000稀释, 4℃ 孵育过夜. 二抗: HRP标记山羊抗小鼠IgG (H+L) (货号GB23301), 1: 5000稀释, 室温孵育1小时. |
|
|
IHC检测Phospho-JNK (T183/Y185)蛋白(货号 GB12018). 样品: 人卵巢癌, 4%多聚甲醛 (货号G1101) 固定12-24小时. 抗原修复: 柠檬酸抗原修复液(干粉, pH 6.0) (G1201), 高压锅均匀喷气计时2分钟. —抗: 1: 1000稀释, 4℃ 孵育过夜. 二抗: HRP标记山羊抗小鼠IgG (H+L) (货号GB23301), 1: 200稀释, 室温孵育1小时. |
|
|
IHC检测Phospho-JNK (T183/Y185)蛋白(货号 GB12018). 样品: 人结肠癌, 4%多聚甲醛 (货号G1101) 固定12-24小时. 抗原修复: 柠檬酸抗原修复液(干粉, pH 6.0) (G1201), 高压锅均匀喷气计时2分钟. —抗: 1: 1000稀释, 4℃ 孵育过夜. 二抗: HRP标记山羊抗小鼠IgG (H+L) (货号GB23301), 1: 200稀释, 室温孵育1小时. |
|
|
IHC检测Phospho-JNK (T183/Y185)蛋白(货号 GB12018). 样品: 人结肠, 4%多聚甲醛 (货号G1101) 固定12-24小时. 抗原修复: 柠檬酸抗原修复液(干粉, pH 6.0) (G1201), 高压锅均匀喷气计时2分钟. —抗: 1: 2000稀释, 4℃ 孵育过夜. 二抗: HRP标记山羊抗小鼠IgG (H+L) (货号GB23301), 1: 200稀释, 室温孵育1小时. |
|
|
IHC检测Phospho-JNK (T183/Y185)蛋白(货号 GB12018). 样品: 人结肠, 4%多聚甲醛 (货号G1101) 固定12-24小时. 抗原修复: 柠檬酸抗原修复液(干粉, pH 6.0) (G1201), 高压锅均匀喷气计时2分钟. —抗: 1: 1000稀释, 4℃ 孵育过夜. 二抗: HRP标记山羊抗小鼠IgG (H+L) (货号GB23301), 1: 200稀释, 室温孵育1小时. |
储存
| 储存条件 | 在-20℃下储存一年, 避免反复冻融. |
| 储存缓冲液 | 含0.15% ProClin300防腐剂, 100 μg/mL牛血清白蛋白和50%甘油的磷酸盐缓冲液. |
注意:
1.本产品仅供研究使用.
2.建议用一抗稀释液(G2025)稀释本产品.
| 货号 | 名称 | 规格 | 价格 | 操作 |
|---|
| 货号 | 名称 | 规格 | 价格 | 操作 |
|---|